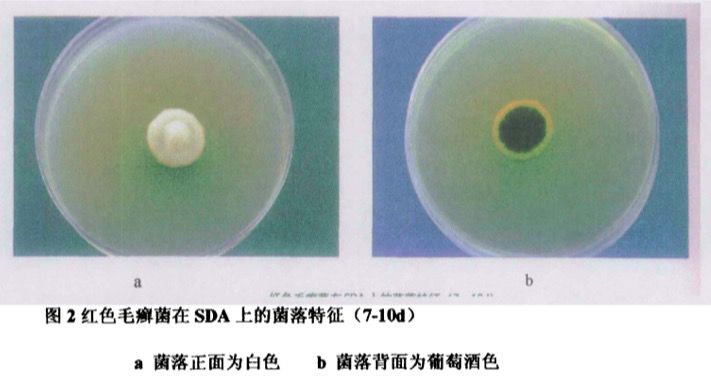
灰指甲反复处理不好根源在哪里,灰指甲治疗需要反复修理甲床吗

有调查表明,灰指甲在人群中的患病率为2%~14%
也就是说周边每一百个人,就可能有2~14人患上灰指甲
灰指甲可发生于任何一个指(趾)甲,趾甲发病率远比指甲为高,其中拇趾甲更是好发部位(发病率高达30%)
他们的指甲可能是这样的:
指甲明显变黄增厚,能明显意识到指甲出现了问题,但可能不知道这就是灰指甲

或者指甲变成了这样的:
甲板下出现浑浊斑色,这是真菌侵蚀造成的
也会有患者误以为是指甲受到外力造成的,选择等待,从而延误灰指甲的治疗

指甲出现浑浊不通透、变黄或者泛白,甲分离、甲凹凸、甲淤血、甲增厚等都是灰指甲的典型症状
临床上也会使用真菌镜检来确诊灰指甲
真菌镜检:将感染甲的最基底部用10-20%的氢氧化钾(KOH) 制片,直接镜检找到孢子或菌丝即可确诊。
当患者确定得了灰指甲,都想要赶紧解决,让指甲恢复健康
但经过一段时间的处理后,有些患者收效甚微,甚至会误以为灰指甲是不治之症
花费了那么多的金钱,也投入了大量的时间
这个灰指甲怎么就如此难根除?
或者说,到底该做到哪些方面,才能彻底战胜灰指甲
ㅤ ㅤ
这就需要先从灰指甲本身说起
通俗一点地讲,灰指甲就是甲菌感染,当指甲受到了外伤,或者接触到了感染菌,个人卫生没有做好
便会沾染上皮肤癣菌、酵母菌或者非皮肤癣菌等致病菌
引起灰指甲的主要癣菌是红色毛癣菌、须癣毛癣菌、絮状表皮癣菌,非皮肤癣菌有其他丝状真菌、白念珠菌、头孢子菌、镰刀菌、短帚衢、土色曲霉、念珠曲霉、黄曲霉等
它们会侵蚀指甲,以角质蛋白为食,逐步让指甲呈现病况,也就是甲真菌病
具体的症状如图所示:

那么为什么难根除?
处理灰指甲,其实就是一个清除感染菌的过程
而很多人感染灰指甲难根除,主要有这几个因素在影响
1. 误判了根除灰指甲需要的时间
这是一个普遍存在的误区
灰指甲确实不是什么严重的疾病,但这并不意味着,其能在很短的时间内得到根除
灰指甲通常的根除时间在3~6个月,其与人体指甲的生长周期密切相关,脚趾的生长周期甚至能长达十个月
有些患者急于求快,用了三四天发现效果甚微,就换另一种办法
结果到最后,换来换去不得根除,这便是对处理时间的典型误判
灰指甲的根除,首要的就是耐心与恒心
2. 感染菌的繁衍能力太强
单以红色毛癣菌为例,其每20分钟繁衍一次,一天可以繁衍47万亿株
生存繁衍能力极强, 不仅会侵蚀甲板与甲床
还会入侵皮肤底层,进行深层侵蚀,还具有一定的传染性
红色毛癣菌或者其他致病菌的清除需要时间,灰指甲的处理时间自然会拉长
3. 指甲坚硬难处理
人的指甲通常可以分为甲根、甲弧影(半月)、甲板、甲床四部分
人的指甲是比较坚硬的,尤其是灰指甲患者的指甲,通常又厚又硬
而寻常的涂抹,其杀菌更多的是针对表层真菌
对于皮肤底层的真菌难以渗透清除
这便会影响灰指甲的处理周期

4. 个人卫生往往被忽视
很多患者并没有使用鞋袜除菌剂的习惯,这无疑会拖长灰指甲的处理时间
要知道感染灰指甲最主要的皮肤癣菌,都是很容易在鞋袜上滋生的
个人好不容易做好了清菌工作,结果一穿鞋袜,清菌效果直接大打折扣
个人卫生的忽视,能直接影响灰指甲的处理时间与效果
灰指甲根除的方法
理清了灰指甲难以根除的具体原因,对应解决即可
这里附上一个成功根除的案例,可供参考:

处理一个月:指甲状况明显改善,恢复光泽

彻底根除:指甲恢复健康状态,周边肌肤无不良影响

问题一:为什么指甲有着色?用什么方法处理的?
使用的是全面浸泡灭菌,指甲着色是因为灭菌汤剂的渗透
相比较涂抹法来讲,使用浸泡灭菌更全面,更容易渗透肌肤进行彻底灭菌
灭菌比较有保障,可以稳定地根除灰指甲问题
问题二:安全吗?会不会对皮肤产生刺激?
使用浸泡法一般来讲,不会对皮肤产生刺激与腐蚀
但也不排除一些产品为了追求根除灰指甲的快速恢复,选择添加比较多的腐蚀性成分
这类产品难免会对皮肤造成腐蚀,需要注意
最后总结:
如果还有什么问题,可以理性探讨
辨明灰指甲难根除的因素,对灰指甲拥有一个充分的认知与了解
其根治自然不会显得很难
做好长时间攻坚战的准备,注意个人卫生与日常的生活习惯,选择适合自己的处理办法,解决即可
ㅤ ㅤ
ㅤ ㅤ
参考文献:
范建宁.甲真菌病临床类型与病原学及中医体质类型构成分析[D].广东:广州中医药大学,2015:3-7.
姚文远.灰指甲挺可怕不治疗麻烦大[J].杏林医话,2018,10:26-27.
王凤华.甲真菌病原菌的分离培养及耐药性实验研究[D].山东:青岛大学,2005:24.
医学百科:灰指甲